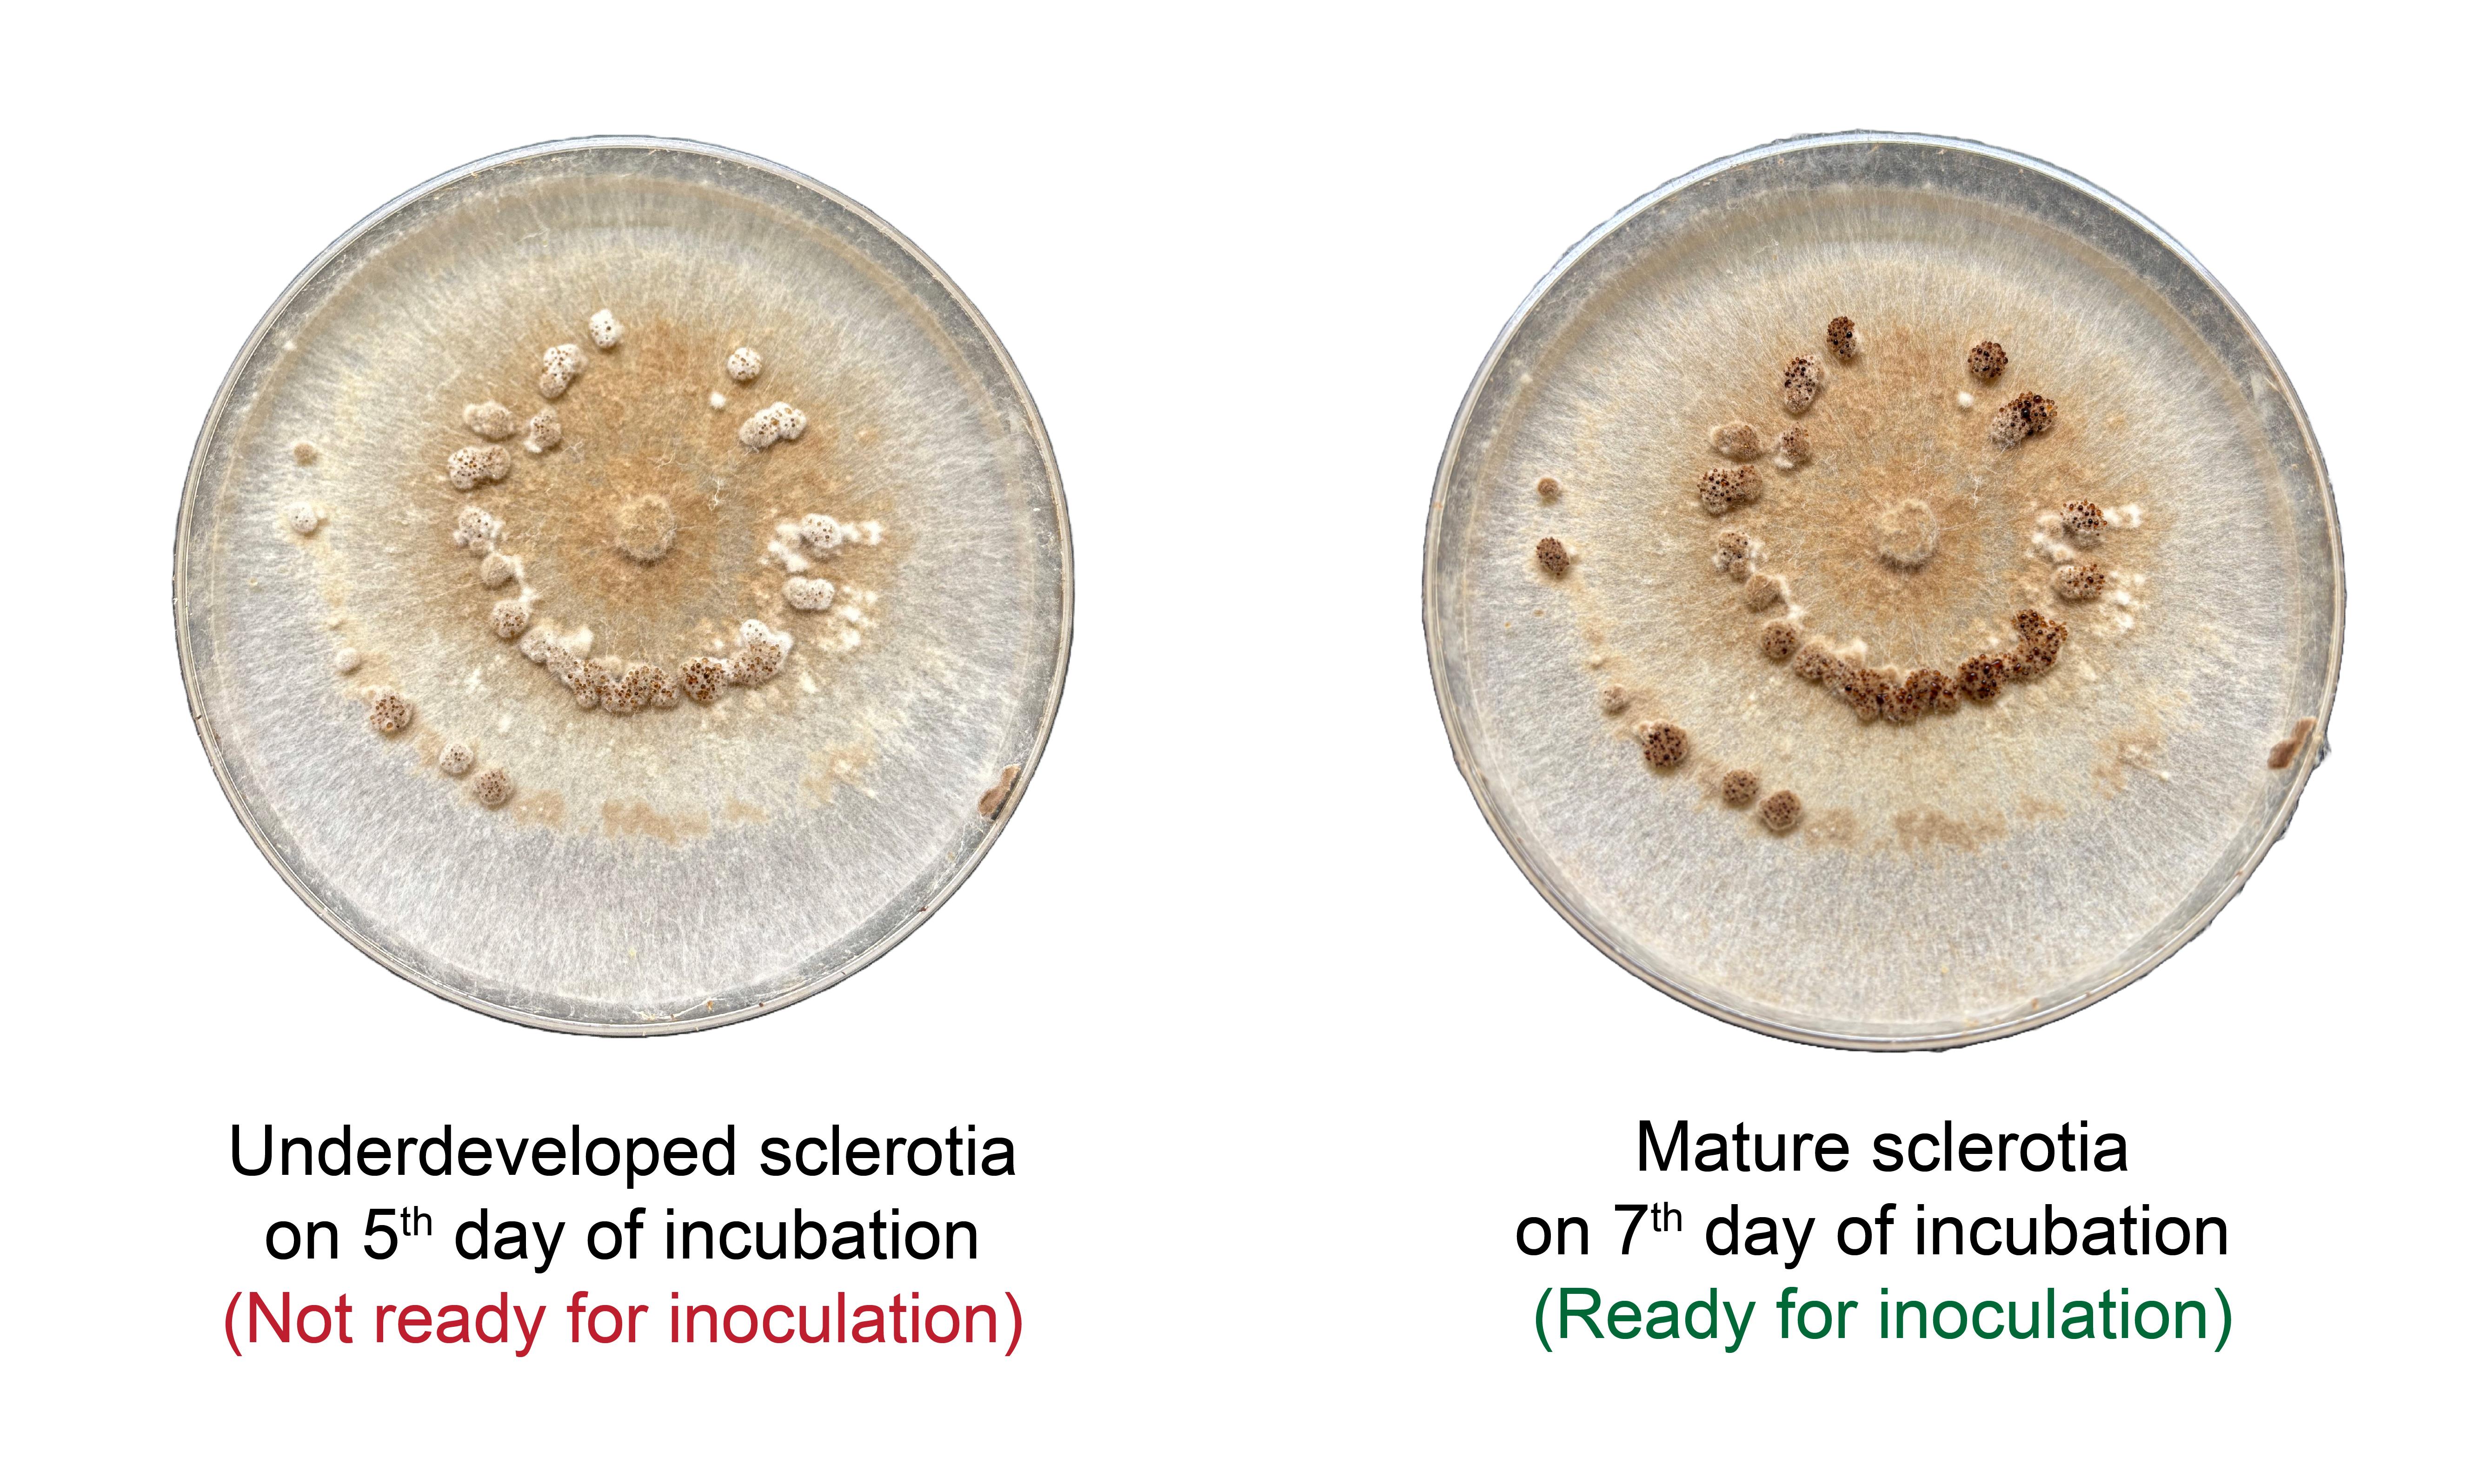

Published: Vol 15, Iss 21, Nov 5, 2025 DOI: 10.21769/BioProtoc.5491 Views: 696
Reviewed by: Shweta PanchalAnonymous reviewer(s)

Protocol Collections
Comprehensive collections of detailed, peer-reviewed protocols focusing on specific topics
Related protocols

In Vitro Hyphal Branching Assay Using Rhizophagus irregularis
Takaya Tominaga and Hironori Kaminaka
Aug 20, 2024 1875 Views

Silencing Arbuscular Mycorrhizal Fungal Gene Using Chitosan Nanoparticle-Mediated dsRNA Delivery System
Chumei Yan [...] Xianan Xie
Jun 5, 2025 2091 Views

In Vitro Screening of Microbial Extracts Against the Oomycetes Phytophthora capsici and Pythium ultimum
Mónica Trigal Martínez [...] María Ángeles Vinuesa Navarro
Sep 20, 2025 733 Views
Abstract
Sheath blight, caused by Rhizoctonia solani, is a major fungal disease of rice that leads to significant yield losses globally. Conventional inoculation methods often fail to achieve consistent and uniform infection, limiting their applicability in antifungal screening studies. This protocol describes a reliable in planta inoculation method for R. solani using mature sclerotia placed at the internodal region of tillering-stage rice seedlings. The procedure includes step-by-step instructions for seed germination, seedling preparation, pathogen culture, artificial inoculation, and post-infection application of antifungal treatments, including botanical compounds such as Ocimum gratissimum essential oil and thymol. Lesion development is monitored and quantified over time, and data are analyzed statistically to evaluate treatment efficacy. The protocol is optimized for reproducibility, scalability, and compatibility with sustainable disease management approaches. It provides a robust platform for evaluating antifungal agents in a biologically relevant and controlled environment.
Key features
• Establishes a reliable in planta inoculation method for R. solani in rice, overcoming the common challenge of achieving consistent disease development.
• Enables post-inoculation screening of botanicals for antifungal efficacy under realistic plant–pathogen interaction conditions.
• Integrates sustainable research practices by detailing botanical extraction and their in planta assessment against R. solani infection.
Keywords: RiceGraphical overview

Background
Rhizoctonia solani Kühn, an economically significant necrotrophic pathogen, is the causal agent of sheath blight in rice (Oryza sativa), one of the most devastating diseases affecting rice cultivation globally [1]. The pathogen infects the leaf sheath and other aerial parts of the plant, especially during the vegetative phase, leading to reduced photosynthetic area, premature senescence, and ultimately substantial yield loss [2]. Despite extensive breeding efforts, no rice cultivar exhibits complete resistance to R. solani, making effective disease management reliant on agronomic practices and chemical control [3]. The in-depth study of the rice–R. solani pathosystem, including host response, virulence mechanisms, and the evaluation of biocontrol or botanical treatments, requires a dependable in planta inoculation method that closely mimics field conditions. However, this has remained a technical challenge due to the pathogen’s facultative saprophytic nature and sensitivity to environmental cues like temperature, humidity, and plant developmental stage.
Various methods have been previously employed to inoculate R. solani under experimental conditions, each with notable limitations. Mycelial plug placement on the leaf sheath is a common method that provides localized infection but lacks uniformity and is labor-intensive for large-scale screening [4]. Soil inoculation using pathogen-colonized rice straw, barley grains, or toothpicks can introduce the pathogen to the plant base but often results in variable infection levels and non-uniform disease progression [5–7]. Spraying of conidial or mycelial suspensions is not feasible in this case, as R. solani does not produce conidia under typical conditions, and foliar application of mycelial fragments tends to dry out quickly, hampering effective colonization [8]. The detached leaf assay is another frequently used approach for preliminary antifungal screenings. While it is rapid and suitable for high-throughput screening, it fails to capture the systemic plant responses and physiological interactions that occur in whole-plant systems, thereby limiting its translational value to field scenarios.
This protocol addresses these issues by providing a step-by-step methodology for consistent in planta inoculation of R. solani in rice at the tillering stage, an important developmental phase when the plant is most susceptible to sheath blight infection. The method ensures robust symptom development by using freshly prepared pathogen cultures placed under controlled humidity and temperature conditions to simulate conducive environments for infection. It is optimized for reproducibility and can be employed for both small- and medium-scale experimental setups. A unique strength of this protocol is its integration with post-inoculation antifungal evaluation using botanical extracts. With increasing concerns over fungicide resistance and environmental toxicity associated with synthetic chemicals, plant-derived antifungal compounds are gaining prominence as eco-friendly alternatives. While several studies have reported in vitro antifungal activity of essential oils and plant extracts against R. solani, their performance in planta remains underexplored. This protocol provides a reliable and biologically relevant framework for assessing the efficacy of such botanicals following real-time infection, thus enhancing the translational significance of in vitro findings.
In addition to antifungal screening, this inoculation method is adaptable for various downstream applications, including microscopy for fungal colonization, gene expression analysis of defense pathways, histochemical staining, and metabolic profiling during pathogen challenge. It thus supports a wide array of studies aimed at understanding host–pathogen dynamics, resistance mechanisms, and the development of sustainable disease control strategies.
Materials and reagents
Biological materials
1. Virulent strain of Rhizoctonia solani OR230677.1 (origin: ARRI, Titabor, Assam, India)
2. Any susceptible rice (Oryza sativa) cultivar such as Swarna (MTU 7029), Samba Mahsuri (BPT 5204), or Pusa Basmati 1 (PB-1)
Reagents
1. Double-distilled water
2. Ethanol 99.5%, analytical grade (Changshu Hongsheng Fine Chemical Co., Ltd)
3. Ocimum gratissimum essential oil (extracted by hydrodistillation using Clevenger type apparatus [9])
4. Thymol (HiMedia, CAS number: GRM7581-100G)
5. Tween 80 (SRL, CAS number: 9005-65-6)
6. Propiconazole (Syngenta, Tilt, CAS number: 60207-90-1)
7. Potato dextrose agar medium (PDA) (HiMedia, CAS number: GM096-500G)
Solutions
1. Potato dextrose agar medium (PDA) (see Recipes)
2. Ethanol (70%) (see Recipes)
3. Tween 80 (0.25%) solution (see Recipes)
4. Ocimum gratissimum essential oil in 0.25% Tween 80 (1,000 ppm) (see Recipes)
5. Thymol in 0.25% Tween 80 (1,000 ppm) (see Recipes)
6. Propiconazole in 0.25% Tween 80 (1,000 ppm) (see Recipes)
Recipes
1. PDA medium
| Reagent | Final concentration | Quantity or volume |
|---|---|---|
| PDA (commercial powder) | 39 g/L | 39 g |
| Double-distilled water | - | Up to 1,000 mL |
| Total | n/a | 1,000 mL |
a. Weigh 39 g of commercially available PDA powder and transfer it to a sterile 1 L borosilicate flask.
b. Add double-distilled water to bring the total volume to 1,000 mL.
c. Stir thoroughly until the powder is completely dissolved. Heat gently if necessary.
d. Adjust the pH to 5.6 ± 0.2 using sterile 1 N NaOH or HCl.
e. Dispense the medium into autoclavable containers and sterilize at 121 °C, 15 psi for 15 min.
f. After sterilization, allow the medium to cool to approximately 50 °C by placing it on the laminar airflow bench with occasional gentle stirring; then, pour into sterile Petri dishes.
g. Store the plates inverted at 4 °C in the dark and use within 2–3 weeks.
2. Ethanol (70%)
| Reagent | Final concentration | Quantity or volume |
|---|---|---|
| Absolute ethanol (≥99.5%) | 70% (v/v) | 700 mL |
| Double-distilled water | 30% (v/v) | 300 mL |
| Total | n/a | 1,000 mL |
a. To prepare 1,000 mL of 70% ethanol, measure 700 mL of absolute ethanol (≥99.5%) using a measuring cylinder and transfer it to a clean, sterile glass beaker.
b. Add 300 mL of double-distilled water to reach a final volume of 1,000 mL.
c. Mix thoroughly by swirling or gentle stirring.
d. Store the solution in a tightly sealed container at room temperature.
e. Label the container with preparation date and concentration.
f. Use freshly prepared solution or store for up to 6 months.
3. Tween 80 (0.25%) solution
| Reagent | Final concentration | Quantity or volume |
|---|---|---|
| Tween 80 | 0.25% (v/v) | 2.5 mL |
| Double-distilled water | - | Up to 1,000 mL |
| Total | n/a | 1,000 mL |
a. To prepare 1,000 mL of 0.25% Tween 80 solution, measure 2.5 mL of Tween 80 using a sterile pipette and add it to approximately 900 mL of double-distilled water in a clean, sterile beaker.
b. Mix thoroughly using a magnetic stirrer or by gentle inversion until the solution is homogeneous.
c. Adjust the final volume to 1,000 mL with additional double-distilled water.
d. Sterilize the solution by autoclaving at 121 °C, 15 psi for 15 min.
e. Store at room temperature or 4 °C, protected from light.
4. Ocimum gratissimum essential oil in 0.25% Tween 80 (1,000 ppm)
| Reagent | Final concentration | Quantity or volume |
|---|---|---|
| Ocimum gratissimum essential oil | 1,000 ppm (v/v) | 1.0 mL |
| 0.25% Tween 80 solution (see Recipe 3) | - | 999 mL |
| Total | n/a | 1,000 mL |
a. To prepare 1,000 mL of Ocimum gratissimum essential oil solution at 1,000 ppm, first prepare 0.25% Tween 80 solution as described in Recipe 3.
b. Then, add 1.0 mL of Ocimum gratissimum essential oil to 999 mL of 0.25% Tween 80 solution.
c. Mix thoroughly using a magnetic stirrer or by vortexing until the oil is uniformly emulsified.
d. Use freshly prepared or store at 4 °C in a sealed amber bottle to protect from light.
5. Thymol in 0.25% Tween 80 (1,000 ppm)
| Reagent | Final concentration | Quantity or volume |
|---|---|---|
| Thymol | 1,000 ppm (w/v) | 1.0 g |
| 0.25% Tween 80 solution (see Recipe 3) | - | 999 mL |
| Total | n/a | 1,000 mL |
a. To prepare 1,000 mL of thymol solution at 1,000 ppm, weigh 1.0 g of thymol and dissolve it in 999 mL of 0.25% Tween 80 solution, prepared as described in Recipe 3.
b. Mix thoroughly by stirring or vortexing until completely dissolved.
c. Store in a sealed container at 4 °C and protect from light.
6. Propiconazole in 0.25% Tween 80 (1,000 ppm)
| Reagent | Final concentration | Quantity or volume |
|---|---|---|
| Propiconazole (a.i.) | 1,000 ppm (v/v) | 1.0 mL |
| 0.25% Tween 80 solution (see Recipe 3) | - | 999 mL |
| Total | n/a | 1,000 mL |
a. To prepare 1,000 mL of propiconazole solution at 1,000 ppm, pipette 1.0 mL of commercial-grade propiconazole (active ingredient, a.i.) and mix into 999 mL of 0.25% Tween 80 solution prepared as described in Recipe 3.
b. Mix thoroughly using a magnetic stirrer or vortex to obtain a uniform solution.
c. Store at 4 °C in a tightly sealed, light-protected container and use within 2 weeks.
Laboratory supplies
1. Plastic pots (15 cm diameter)
2. Sterile Petri dishes (Tarson, catalog number: 100 mm PP Autoclavable Petri Dish 46203)
3. Sterile muslin cloth (Euqinu 1 × 1 Meter Cotton Muslin Cloth, Ultra Fine Fabric)
4. Sterile forceps (Vandersluys normal tip forceps)
5. Sterile scalpel or inoculation loop (Tarsons, catalog number: 920051)
6. Sterile needle (Thomas Scientific, needle with nichrome wire)
7. Hand sprayers (one per treatment) (1.5 L Garden Agriculture Spray Pump Atomizer Compression Pressure Sprayer)
8. pH indicator strips (Parshv, model number: P.H. [Universal] Indicator Paper)
9. Measuring cylinders (100 mL) (Borosil, catalog number: 3022016)
10. Transparent ruler or digital caliper (UniMarket, model number: UniMarketCH2-9MDPD26T)
11. Borosilicate glass flasks (1 L) (Borosil, catalog number: 5360029)
12. Sterile beakers (1,000 mL) (Borosil, model number: ZGB-08)
13. Micropipettes (10 µL, 20 µL, 200 µL, 1,000 µL) (Tarsons)
14. Corresponding sterile pipette tips (10 µL, 20 µL, 200 µL, 1,000 µL) (Tarsons)
15. Disposable gloves
16. Laboratory masks (AMPri, catalog number: 081307-L)
17. Lab coat
18. Waste disposal bags
Equipment
1. Greenhouse or plant growth chamber with environmental control (temperature, humidity, light cycle) (iGene, model number: IG-150GC)
2. Incubator (capable of maintaining 33 °C) (GENEXIS, model: GLA-109-2)
3. Autoclave (for sterilization at 121 °C, 15 psi) (EQUITRON, model: Portable PAD)
4. Magnetic stirrer with stir bars (REMI, model: 2-MLH)
5. pH meter (Mettler-Toledo GmbH, model: FP20)
6. Analytical balance (SCALETEC, model: SAB-203L)
7. Vortex mixer (Ambinova, model: AMBI-VM-01)
8. Laminar airflow cabinet (for aseptic work) (Ambinova, model: AMBI-LAF-3999HE)
9. Refrigerator (4 °C, for media and inoculum storage) (SAMSUNG, model: RT39B551ES8/HL)
10. Digital camera (for lesion imaging and documentation)
Software and datasets
1. RStudio (Posit, version 2025.05.1+513)
Procedure
A. Rice seed germination
1. Soak rice seeds in clean, double-distilled water in a sterile beaker at room temperature (25–28 °C) for 24 h to initiate dormancy breaking.
Note: Ensure seeds are fully submerged and kept in a clean, covered container to prevent contamination.
2. After 24 h, drain the water and wrap the soaked seeds in a moist, sterile muslin cloth.
3. Place the wrapped seeds in a warm, dark incubator or chamber set to 33 °C for 48 h to promote pre-germination.
Critical: Maintain moisture in the cloth throughout incubation to prevent seed desiccation.
4. After 48 h, check for radicle emergence. Select seeds with radicles 1–2 mm in length for sowing.
B. Seedling establishment and growth for R. solani challenge
1. Prepare plastic pots (10 cm diameter) with a sterilized 3:1 mix of loamy soil (any well-drained loam) and compost (well-decomposed farmyard manure or vermicompost); the source does not affect the experiment.
2. Sow 5 pre-germinated seeds per pot, embedding them approximately 1 cm deep.
3. Arrange pots in a greenhouse or plant growth chamber maintained at 28 °C with a 12/12 h light/dark cycle.
4. Maintain relative humidity at 80%–100% during the early seedling stage using humidifiers or transparent covers.
5. Water pots twice daily (morning and late afternoon) to maintain a stagnant water condition in the pots.
6. Allow seedlings to grow for 40 days. Select healthy, vigorous, green seedlings for pathogen inoculation.
Pause point: Remove the excess water from the pots before inoculation. Seedlings can be maintained under these conditions for up to 45 days if necessary.
C. Preparation of Rhizoctonia solani inoculum
1. Inoculate Rhizoctonia solani sclerotium onto freshly prepared PDA medium (see Recipe 1) in sterile Petri dishes under aseptic conditions.
2. Incubate the inoculated plates at 28 °C in the dark for 7 days to allow active mycelial growth and sclerotia formation.
3. After 7 days, confirm the presence of mature, black-brown sclerotia on the culture surface.
4. Using a sterile scalpel or inoculation loop, aseptically scrape and collect mature sclerotia from the culture surface and transfer them directly to a sterilized Petri dish (no water is used during harvesting) (Figure 1).
Critical: Select only fully developed, dark-colored sclerotia to ensure high viability and effective infection (Figure 2).
5. Store the harvested sclerotia in sterile Petri dishes under dry conditions, sealed with parafilm, at 4 °C until use.
Note: Use the inoculum within 24 h of harvesting to maintain maximum pathogenic potential.

D. Artificial inoculation and antifungal compound application
1. At the tillering stage (40-day-old seedlings), gently lift the leaf sheath to expose the internodal region.
2. Using a sterilized needle, carefully pierce the internodal region just above the soil line (Figure 1).
3. Using sterile forceps, place a single sclerotium at the site of injury and reposition the sheath to cover the site (Figure 1).
Critical: Ensure firm contact between the sclerotium and the pierced tissue to facilitate infection. Do not remove the sheath completely during inoculation. Make the injury near the water level, where sheath blight symptoms typically develop.
4. Arrange treatments in a completely randomized design (CRD) with at least three replicates per treatment (minimum five pots per replication and five seedlings per pot).
5. After 24 h (day 41), begin treatment with antifungal agents by foliar spray using a hand sprayer applying a fine mist uniformly over the whole plant (both sheath and leaves) from a distance of approximately 10–30 cm to ensure even coverage without runoff (Figure 1).
6. Apply one of the following treatments to separate sets of inoculated plants:
Ocimum gratissimum essential oil (1,000 ppm in 0.25% Tween 80)
Thymol (1,000 ppm in 0.25% Tween 80)
Propiconazole (1,000 ppm in 0.25% Tween 80) as positive control
Negative control: spray with 0.25% Tween 80
Absolute control: uninoculated plants
Note: This protocol is adaptable for testing other plant-derived or synthetic compounds with potential antifungal activity. Adjust concentrations and formulations based on minimum inhibitory concentration, solubility, and phytotoxicity considerations, and apply them using the same treatment schedule.
7. Repeat spraying on alternate days for a total of three applications (days 41, 43, and 45).
Note: Use a new, sterile sprayer for each treatment to prevent cross-contamination.
E. Plant maintenance and disease monitoring
1. Maintain inoculated and treated rice plants under controlled conditions: 28 °C, 12/12 h light/dark cycle, and 80%–90% relative humidity throughout the experimental period.
2. Observe plants daily for the development of sheath blight symptoms starting from 4 days post-inoculation (dpi). Water-soaked lesions typically begin to appear at the inoculation site by day 45 (Figure 3).
Note: Symptom expression may vary slightly depending on cultivar sensitivity and environmental fluctuations. Occasional algal growth on the soil surface may also occur under high humidity; this is a common observation and does not affect disease development or the outcome of the experiment.
3. Measure lesion diameters at 4, 6, 8, and 10 dpi using a sterile ruler or digital caliper (Figure 1).
Critical: Always measure the widest part of each lesion and record the value in millimeters. Perform measurements at the same time each day to reduce variability caused by diurnal changes.
4. Record lesion measurements for each pot (biological replicate) in a structured data sheet. Include treatment group, replicate number, and dpi for each observation.
Note: If multiple lesions are present on a single plant, measure a representative lesion or calculate the average to standardize the dataset.

Data analysis
Enter the recorded data into a structured spreadsheet, labeling treatment groups, replicate numbers, and time points. Perform statistical analysis using RStudio. Use one-way analysis of variance (ANOVA) to evaluate treatment effects at individual time points. When analyzing the combined influence of treatment and time, or their interaction, apply two-way ANOVA. Set the significance threshold at p < 0.05. When significant differences are detected, conduct post hoc comparisons using Tukey’s honest significant difference (HSD) test to determine which groups differ. Visualize the results using appropriate data plots generated with R packages such as ggplot2 and dplyr. Include axis labels, units, dpi values, treatment identifiers, and appropriate indicators of variation such as standard deviation or standard error. Annotate figures with statistical groupings where applicable.
Validation of protocol
This protocol has been used and validated in the following research article:
Yasin et al. [9] Thymol rich essential oil from Assam ecotype of Ocimum gratissimum as a biocontrol agent for sheath blight disease of rice. Biocatalysis and Agricultural Biotechnology (Figures 6, 7, and 8).
General notes and troubleshooting
General notes
1. Use freshly prepared inoculum and treatments for optimal reproducibility. Sclerotia of R. solani should be harvested from actively growing PDA cultures no more than 24 h before inoculation to maintain viability and pathogenicity.
2. The protocol is optimized for susceptible rice cultivars at the tillering stage. Application to other cultivars or developmental stages may require adjustments to the inoculation method and incubation conditions.
3. Antifungal agents must be emulsified uniformly in 0.25% Tween 80 and either freshly prepared or stored at 4 °C in amber bottles to preserve efficacy. Shake thoroughly before use to re-emulsify oils that may have separated during storage.
4. This protocol may be adapted for screening additional plant-based antifungal agents or for genetic and molecular studies involving host–pathogen interaction by incorporating relevant assays post-infection (e.g., qPCR, microscopy, metabolomics).
5. Plant-to-plant variability within a single pot can influence lesion size measurements. Always average lesion data across plants within each replicate for more accurate statistical analysis.
6. Precise measurement of lesions is essential. Use consistent tools (e.g., transparent ruler or digital caliper), and measure at the widest point of the lesion to reduce observer bias.
Troubleshooting
Problem 1: Lesions do not appear on inoculated plants.
Possible cause: Inoculum is non-viable or improperly placed.
Solution: Use freshly harvested sclerotia from active PDA cultures. Ensure direct contact between the sclerotium and the wounded internodal region under the sheath.
Problem 2: Contamination of PDA media or Tween 80 solutions.
Possible cause: Non-sterile technique or expired stock.
Solution: Use autoclaved media and freshly prepared sterile solutions. Perform all transfers and inoculations inside a laminar flow hood or clean bench.
Acknowledgments
1) Specific contributions of each author, Conceptualization, A.Y., AK.; Investigation, A.Y., J.D., A.K., S.S., P.B.; Writing—Original Draft, A.Y., A.K.; Writing—Review & Editing, B.D., A.K., B.C.N., P.N.B., P.D.; Funding acquisition, A.K.; Supervision, A.K. 2) This research work is funded by the grant received from the Department of Science and Technology, Govt. of India under Technology Development Programme (DST Project Ref. No: TPN/77754). 3) The authors acknowledge the work published from the lab in which the protocol was described and validated [9].
Competing interests
The authors declare that they have no competing interests.
References
Article Information
Publication history
Received: Jun 28, 2025
Accepted: Sep 16, 2025
Available online: Oct 14, 2025
Published: Nov 5, 2025
Copyright
© 2025 The Author(s); This is an open access article under the CC BY-NC license (https://creativecommons.org/licenses/by-nc/4.0/).
How to cite
Yasin, A., Kashyap, A., Dowarah, B., Dey, J., Bharali, S., Nath, B. C., Bhattacharyya, P. N., Sharma, S., Barua, P. and Nath, P. D. (2025). A Reliable In Planta Inoculation and Antifungal Screening Protocol for Rhizoctonia solani-Induced Sheath Blight in Rice. Bio-protocol 15(21): e5491. DOI: 10.21769/BioProtoc.5491.
Category
Plant Science > Plant immunity > Host-microbe interactions
Microbiology > Microbe-host interactions > Fungus
Do you have any questions about this protocol?
Post your question to gather feedback from the community. We will also invite the authors of this article to respond.
Tips for asking effective questions
+ Description
Write a detailed description. Include all information that will help others answer your question including experimental processes, conditions, and relevant images.
Share
Bluesky
X
Copy link
